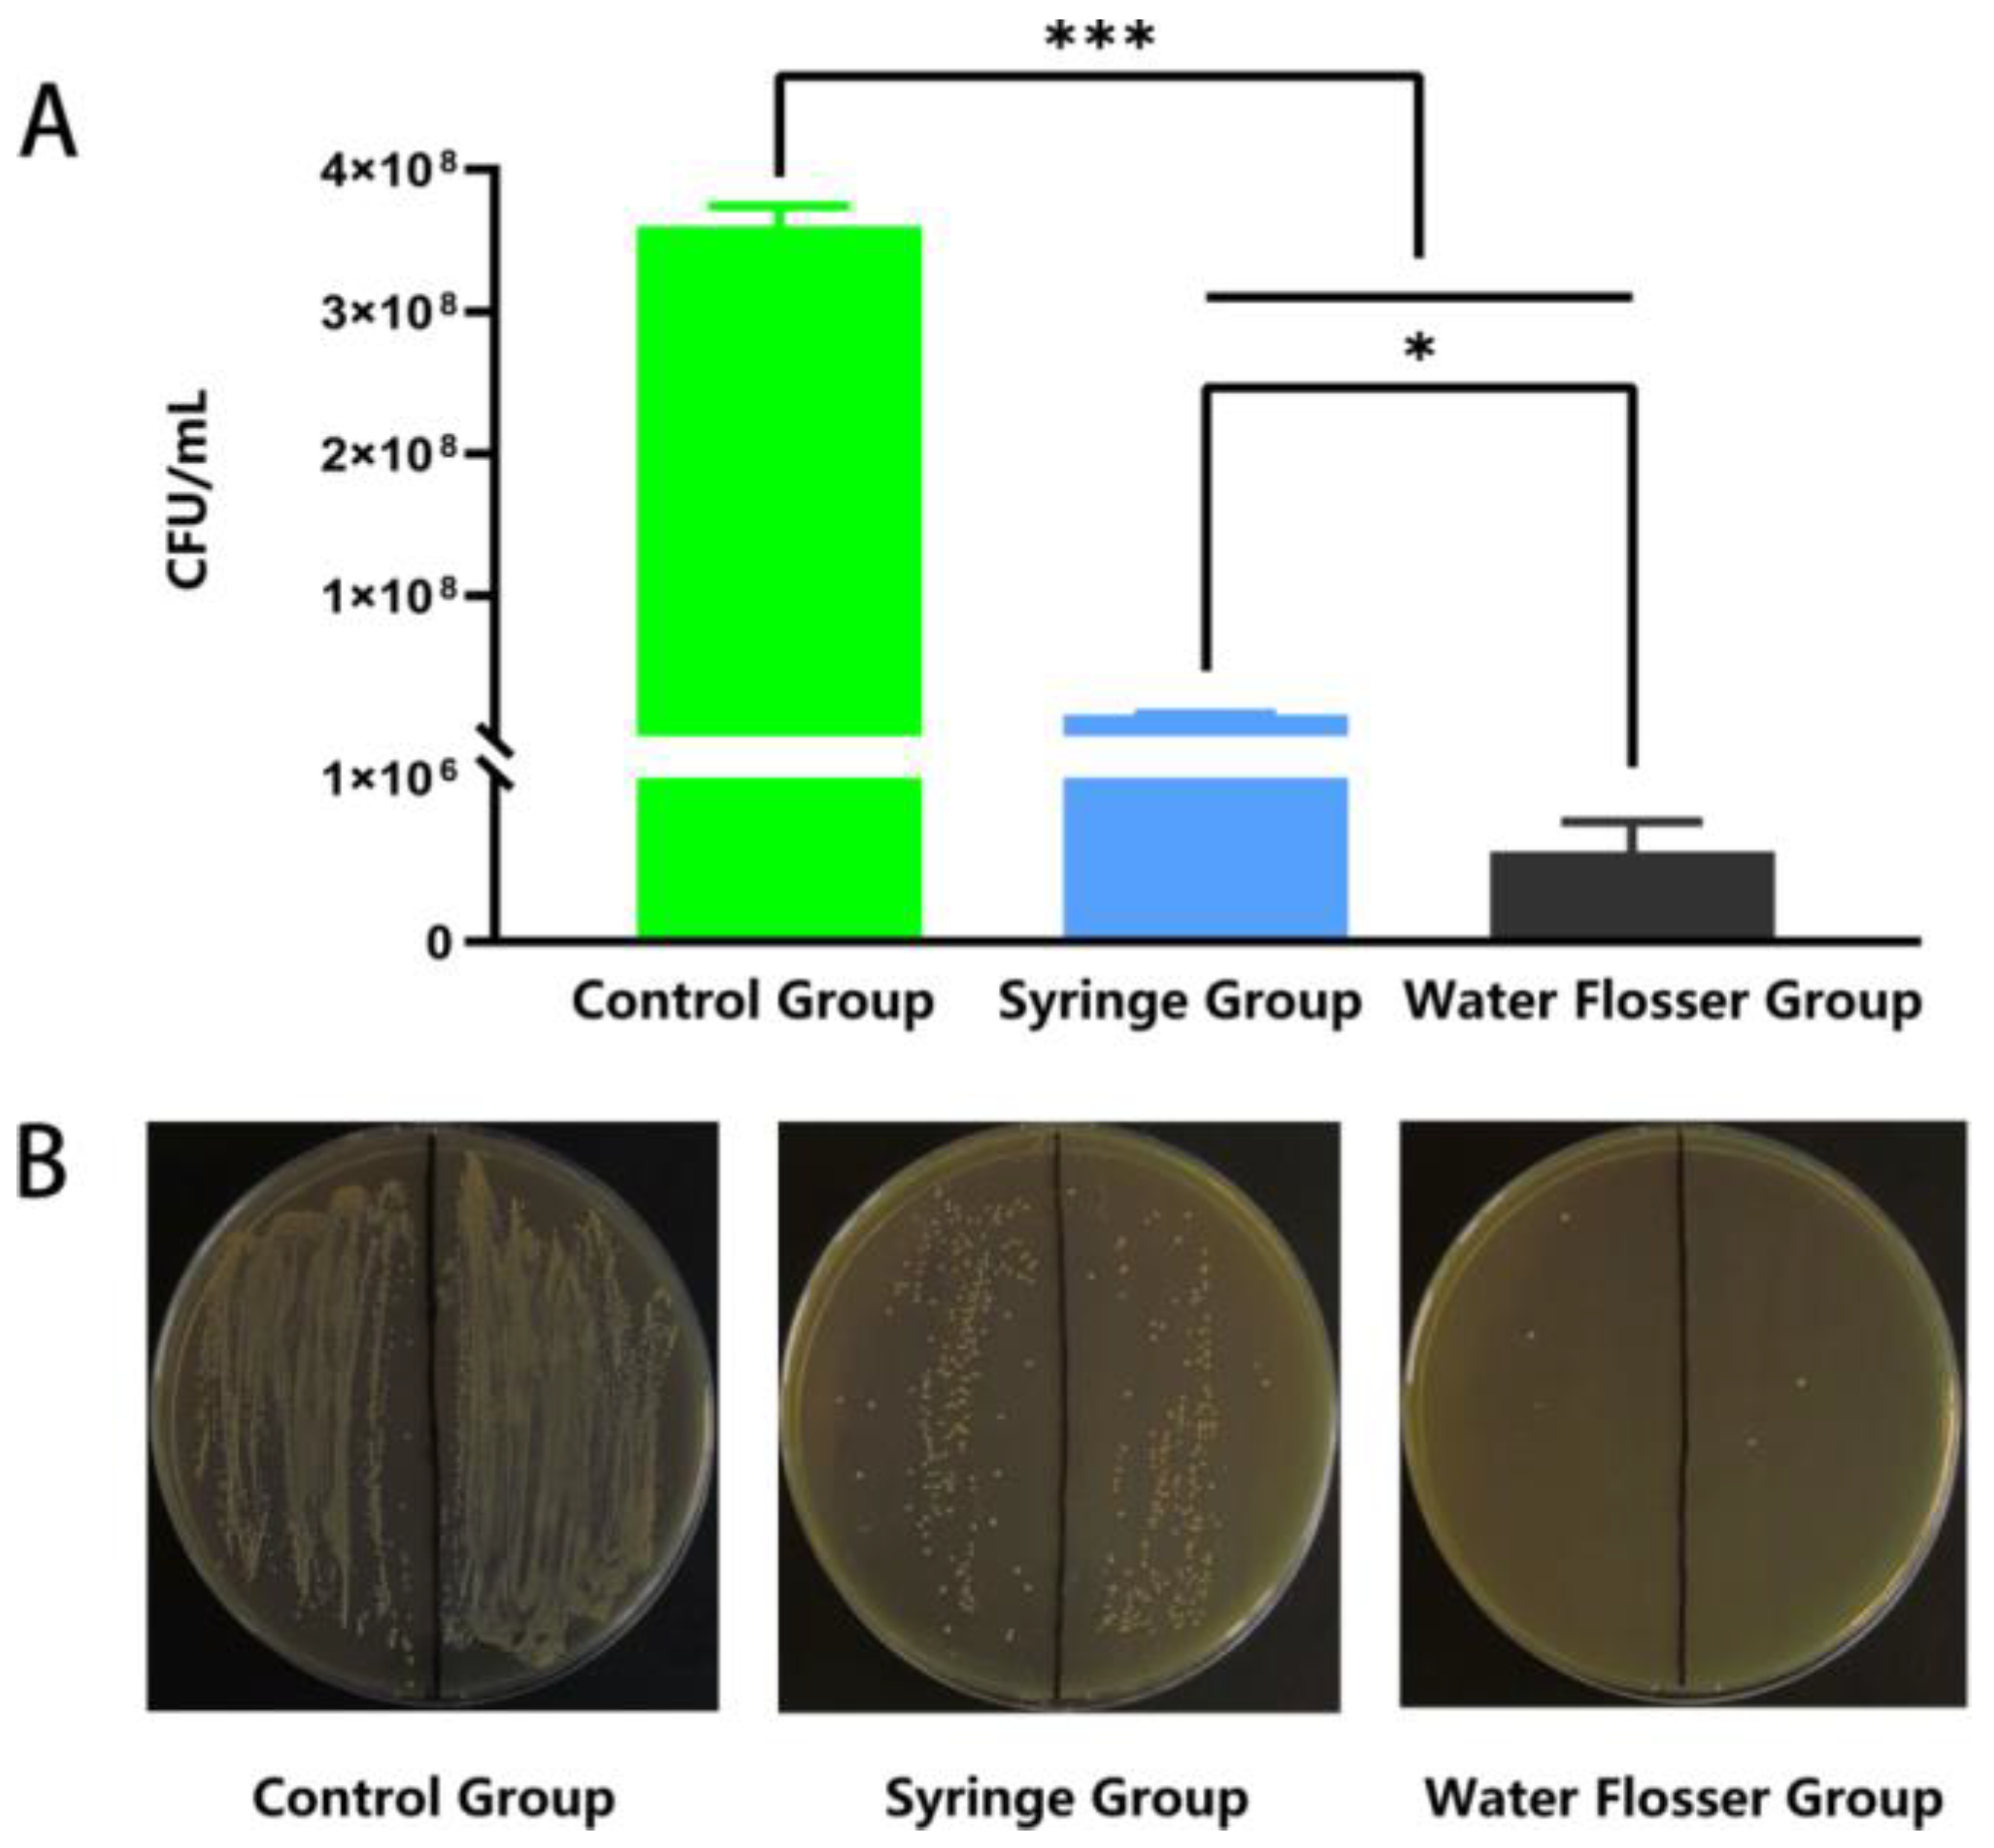
Bioengineering 10 01061 g005 Bioengineering 10 01061 g005

Efficient Removal of Dental Plaque Biofilm from Training Typodont Teeth via Water Flosser
Abstract
1. Introduction
2. Materials and Methods
2.1. Materials
2.2. Removal of Adhered Sucrose Using Water Flosser and Syringe
2.3. Bacterial Growth Conditions
2.4. Bacterial Growth Curves in Different Temperature
2.5. Biofilm Growth Conditions
2.6. Removal of Biofilms Using Water Flosser and Syringe
2.7. Crystal Violet (CV) Staining
2.8. Quantitative Assessment of Biofilm Removal
2.9. Scanning Electron Microscopy (SEM)
2.10. Statistics
3. Results and Discussion
3.1. Sucrose Removal
3.2. Bacterial Growth Curves
3.3. General Assessment of Biofilm Removal
3.4. Quantitative Assessment of Biofilm Removal
3.5. SEM Examination
4. Conclusions
Author Contributions
Funding
Institutional Review Board Statement
Informed Consent Statement
Data Availability Statement
Conflicts of Interest
References
- Pitts, N.B.; Zero, D.T.; Marsh, P.D.; Ekstrand, K.; Weintraub, J.A.; Ramos-Gomez, F.; Tagami, J.; Twetman, S.; Tsakos, G.; Ismail, A. Dental caries. Nat. Rev. Dis. Primers 2017, 3, 17030. [Google Scholar] [CrossRef] [PubMed]
- Zhu, T.; Huang, Z.; Shu, X.; Zhang, C.; Dong, Z.; Peng, Q. Functional nanomaterials and their potentials in antibacterial treatment of dental caries. Colloids Surf. B Biointerfaces 2022, 218, 112761. [Google Scholar] [CrossRef] [PubMed]
- Gao, H.; Wu, N.; Wang, N.; Li, J.; Sun, J.; Peng, Q. Chitosan-based therapeutic systems and their potentials in treatment of oral diseases. Int. J. Biol. Macromol. 2022, 222, 3178–3194. [Google Scholar] [CrossRef]
- Sabharwal, A.; Stellrecht, E.; Scannapieco, F.A. Associations between dental caries and systemic diseases: A scoping review. BMC Oral Health 2021, 21, 1–35. [Google Scholar] [CrossRef] [PubMed]
- Yan, R.; Liu, J.; Dong, Z.; Peng, Q. Nanomaterials-mediated photodynamic therapy and its applications in treating oral diseases. Biomater. Adv. 2023, 144, 213218. [Google Scholar] [CrossRef]
- Wen, P.Y.F.; Chen, M.X.; Zhong, Y.J.; Dong, Q.Q.; Wong, H.M. Global Burden and Inequality of Dental Caries, 1990 to 2019. J. Dent. Res. 2022, 101, 392–399. [Google Scholar] [CrossRef]
- Li, Z.-R.; Sun, J.; Du, Y.; Pan, A.; Zeng, L.; Maboudian, R.; Burne, R.A.; Qian, P.-Y.; Zhang, W. Mutanofactin promotes adhesion and biofilm formation of cariogenic Streptococcus mutans. Nat. Chem. Biol. 2021, 17, 576–584. [Google Scholar] [CrossRef]
- Carda-Diéguez, M.; Moazzez, R.; Mira, A. Functional changes in the oral microbiome after use of fluoride and arginine containing dentifrices: A metagenomic and metatranscriptomic study. Microbiome 2022, 10, 159. [Google Scholar] [CrossRef]
- Jiao, Y.; Tay, F.R.; Niu, L.N.; Chen, J.H. Advancing antimicrobial strategies for managing oral biofilm infections. Int. J. Oral Sci. 2019, 11, 28. [Google Scholar] [CrossRef]
- Aires, C.; Cury, A.D.B.; Tenuta, L.; Klein, M.; Koo, H.; Duarte, S.; Cury, J. Effect of starch and sucrose on dental biofilm formation and on root dentine demineralization. Caries Res. 2008, 42, 380–386. [Google Scholar] [CrossRef]
- Karygianni, L.; Ren, Z.; Koo, H.; Thurnheer, T. Biofilm Matrixome: Extracellular Components in Structured Microbial Communities. Trends Microbiol. 2020, 28, 668–681. [Google Scholar] [CrossRef] [PubMed]
- Bowen, W.H.; Burne, R.A.; Wu, H.; Koo, H. Oral Biofilms: Pathogens, Matrix, and Polymicrobial Interactions in Microenvironments. Trends Microbiol. 2018, 26, 229–242. [Google Scholar] [CrossRef] [PubMed]
- Manti, A.; Ciandrini, E.; Campana, R.; Dominici, S.; Ciacci, C.; Federici, S.; Sisti, D.; Rocchi, M.B.; Papa, S.; Baffone, W. A dual-species microbial model for studying the dynamics between oral streptococci and periodontal pathogens during biofilm development on titanium surfaces by flow cytometry. Res. Microbiol. 2016, 167, 393–402. [Google Scholar] [CrossRef] [PubMed]
- Bombarda, G.F.; Rosalen, P.L.; Paganini, E.R.; Garcia, M.A.; Silva, D.R.; Lazarini, J.G.; Freires, A.I.; Regasini, L.O.; Sardi, J.C. Bioactive molecule optimized for biofilm reduction related to childhood caries. Future Microbiol. 2019, 14, 1207–1220. [Google Scholar] [CrossRef] [PubMed]
- de Oliveira, M.A.; da CVegian, M.R.; Brighenti, F.L.; Salvador, M.J.; Koga-Ito, C.Y. Antibiofilm effects of Thymus vulgaris and Hyptis spicigera essential oils on cariogenic bacteria. Future Microbiol. 2021, 16, 241–255. [Google Scholar] [CrossRef]
- Cai, J.N.; Choi, H.M.; Jeon, J.G. Relationship between sucrose concentration and bacteria proportion in a multispecies biofilm: Short title: Sucrose challenges to a multispecies biofilm. J. Oral Microbiol. 2021, 13, 1910443. [Google Scholar] [CrossRef]
- Catala-Valentin, A.; Bernard, J.N.; Caldwell, M.; Maxson, J.; Moore, S.D.; Andl, C.D. E-Cigarette Aerosol Exposure Favors the Growth and Colonization of Oral Streptococcus mutans Compared to Commensal Streptococci. Microbiol. Spectr. 2022, 10, e0242121. [Google Scholar] [CrossRef]
- Zhu, B.; Macleod, L.C.; Kitten, T.; Xu, P. Streptococcus sanguinis biofilm formation & interaction with oral pathogens. Future Microbiol. 2018, 13, 915–932. [Google Scholar]
- Xiong, K.; Zhu, H.; Li, Y.; Ji, M.; Yan, Y.; Chen, X.; Chi, Y.; Yang, X.; Deng, L.; Zhou, X.; et al. The Arginine Biosynthesis Pathway of Candida albicans Regulates Its Cross-Kingdom Interaction with Actinomyces viscosus to Promote Root Caries. Microbiol. Spectr. 2022, 10, e0078222. [Google Scholar] [CrossRef]
- Deng, L.; Li, W.; He, Y.; Wu, J.; Ren, B.; Zou, L. Cross-kingdom interaction of Candida albicans and Actinomyces viscosus elevated cariogenic virulence. Arch. Oral Biol. 2019, 100, 106–112. [Google Scholar] [CrossRef]
- Urmi, A.S.; Inaba, H.; Nomura, R.; Yoshida, S.; Ohara, N.; Asai, F.; Nakano, K.; Matsumoto-Nakano, M. Roles of Porphyromonas gulae proteases in bacterial and host cell biology. Cell Microbiol. 2021, 23, e13312. [Google Scholar] [CrossRef] [PubMed]
- Abram, A.M.; Szewczyk, M.M.; Park, S.G.; Sam, S.S.; Eldana, H.B.; Koria, F.J.; Ferracciolo, J.M.; Young, L.A.; Qadir, H.; Bonham, A.J.; et al. A Co-Association of Streptococcus mutans and Veillonella parvula/dispar in Root Caries Patients and In Vitro Biofilms. Infect. Immun. 2022, 90, e0035522. [Google Scholar] [CrossRef]
- Figuero, E.; Nóbrega, D.F.; García-Gargallo, M.; Tenuta, L.M.A.; Herrera, D.; Carvalho, J.C. Mechanical and chemical plaque control in the simultaneous management of gingivitis and caries: A systematic review. J. Clin. Periodontol. 2017, 44, S116–S134. [Google Scholar] [CrossRef] [PubMed]
- Toumba, K.; Twetman, S.; Splieth, C.; Parnell, C.; Van Loveren, C.; Lygidakis, N. Guidelines on the use of fluoride for caries prevention in children: An updated EAPD policy document. Eur. Arch. Paediatr. Dent. 2019, 20, 507–516. [Google Scholar] [CrossRef]
- Braga, A.S.; Simas, L.L.M.; Pires, J.G.; Souza, B.M.; de Melo, F.P.S.R.; Saldanha, L.L.; Dokkedal, A.L.; Magalhães, A.C. Antibiofilm and anti-caries effects of an experimental mouth rinse containing Matricaria chamomilla L. extract under microcosm biofilm on enamel. J. Dent. 2020, 99, 103415. [Google Scholar] [CrossRef] [PubMed]
- Yao, K.; Yao, Y.; Shen, X.; Lu, C.; Guo, Q. Assessment of the oral health behavior, knowledge and status among dental and medical undergraduate students: A cross-sectional study. BMC Oral Health 2019, 19, 1–8. [Google Scholar] [CrossRef]
- Digel, I.; Kern, I.; Geenen, E.M.; Akimbekov, N. Dental plaque removal by ultrasonic toothbrushes. Dent. J. 2020, 8, 28. [Google Scholar] [CrossRef]
- Offin, D.G.; Birkin, P.R.; Leighton, T.G. An electrochemical and high-speed imaging study of micropore decontamination by acoustic bubble entrapment. Phys. Chem. Chem. Phys. 2014, 16, 4982–4989. [Google Scholar] [CrossRef][Green Version]
- Schaffer, S.D.; Hutchison, C.A.; Rouchon, C.N.; Mdluli, N.V.; Weinstein, A.J.; McDaniel, D.; Frank, K.L. Diverse Enterococcus faecalis strains show heterogeneity in biofilm properties. Res. Microbiol. 2022, 174, 103986. [Google Scholar] [CrossRef]
- Carrera-Salinas, A.; Gonzalez-Diaz, A.; Antonio Vazquez-Sanchez, D.; Camoez, M.; Niubo, J.; Camara, J.; Ardanuy, C.; Martí, S.; Domínguez, M.Á.; REIPI/GEIH Study Groups. Staphylococcus aureus surface protein G (sasG) allelic variants: Correlation between biofilm formation and their prevalence in methicillin-resistant S. aureus (MRSA) clones. Res. Microbiol. 2022, 173, 103921. [Google Scholar] [CrossRef]
- Zhu, G.-Y.; Lu, B.-Y.; Zhang, T.-X.; Zhang, T.; Zhang, C.-L.; Li, Y.; Peng, Q. Antibiofilm effect of drug-free and cationic poly(D,L-lactide-co-glycolide) nanoparticles via nano–bacteria interactions. Nanomedicine 2018, 13, 1093–1106. [Google Scholar] [CrossRef]
- Silvestre, I.; Borrego, M.J.; Jordao, L. Biofilm formation by ST17 and ST19 strains of Streptococcus agalactiae. Res. Microbiol. 2020, 171, 311–318. [Google Scholar] [CrossRef] [PubMed]
- Zwietering, M.; Jongenburger, I.; Rombouts, F.; Van’t Riet, K. Modeling of the bacterial growth curve. Appl. Environ. Microbiol. 1990, 56, 1875–1881. [Google Scholar] [CrossRef] [PubMed]
- Ricci, S.; Pinette, M.G.; Wax, J.R.; Craig, W.; Forrest, L.; Dragoni, C. The effect of temperature on bacterial growth in the presence of nonsterile ultrasound coupling gel. Am. J. Obstet. Gynecol. 2020, 222, 188. [Google Scholar] [CrossRef] [PubMed]
- Wang, L.H.; Chen, L.; Zhao, S.; Huang, Y.; Zeng, X.A.; Aadil, R.M. Inactivation efficacy and mechanisms of atmospheric cold plasma on Alicyclobacillus acidoterrestris: Insight into the influence of growth temperature on survival. Front. Nutr. 2022, 9, 1012901. [Google Scholar] [CrossRef]
- Dey, A.; Bokka, V.; Sen, S. Dependence of bacterial growth rate on dynamic temperature changes. IET Syst. Biol. 2020, 14, 68–74. [Google Scholar] [CrossRef]
- Teleken, J.T.; Galvão, A.C.; Robazza, W.D.S. Use of modified Richards model to predict isothermal and non-isothermal microbial growth. Braz. J. Microbiol. 2018, 49, 614–620. [Google Scholar] [CrossRef]
- Frey, P.M.; Baer, J.; Bergada-Pijuan, J.; Lawless, C.; Bühler, P.K.; Kouyos, R.D.; Lemon, K.P.; Zinkernagel, A.S.; Brugger, S.D. Quantifying Variation in Bacterial Reproductive Fitness: A High-Throughput Method. mSystems 2021, 6, e01323-20. [Google Scholar] [CrossRef]
- Graham, C.; Harmand, J.; Méléard, S.; Tchouanti, J. Bacterial metabolic heterogeneity: From stochastic to deterministic models. Math. Biosci. Eng. 2020, 17, 5120–5133. [Google Scholar] [CrossRef]

Disclaimer/Publisher’s Note: The statements, opinions and data contained in all publications are solely those of the individual author(s) and contributor(s) and not of MDPI and/or the editor(s). MDPI and/or the editor(s) disclaim responsibility for any injury to people or property resulting from any ideas, methods, instructions or products referred to in the content. |
© 2023 by the authors. Licensee MDPI, Basel, Switzerland. This article is an open access article distributed under the terms and conditions of the Creative Commons Attribution (CC BY) license (https://creativecommons.org/licenses/by/4.0/).
Share and Cite
Wang, Y.; Gao, H.; Chang, L.; Xu, J.; Zhou, X.; Zhang, C.; Peng, Q. Efficient Removal of Dental Plaque Biofilm from Training Typodont Teeth via Water Flosser. Bioengineering 2023, 10, 1061. https://doi.org/10.3390/bioengineering10091061
Wang Y, Gao H, Chang L, Xu J, Zhou X, Zhang C, Peng Q. Efficient Removal of Dental Plaque Biofilm from Training Typodont Teeth via Water Flosser. Bioengineering. 2023; 10(9):1061. https://doi.org/10.3390/bioengineering10091061
Chicago/Turabian StyleWang, Yue, Hongyu Gao, Lili Chang, Jingchen Xu, Xueer Zhou, Chaoliang Zhang, and Qiang Peng. 2023. "Efficient Removal of Dental Plaque Biofilm from Training Typodont Teeth via Water Flosser" Bioengineering 10, no. 9: 1061. https://doi.org/10.3390/bioengineering10091061
APA StyleWang, Y., Gao, H., Chang, L., Xu, J., Zhou, X., Zhang, C., & Peng, Q. (2023). Efficient Removal of Dental Plaque Biofilm from Training Typodont Teeth via Water Flosser. Bioengineering, 10(9), 1061. https://doi.org/10.3390/bioengineering10091061

